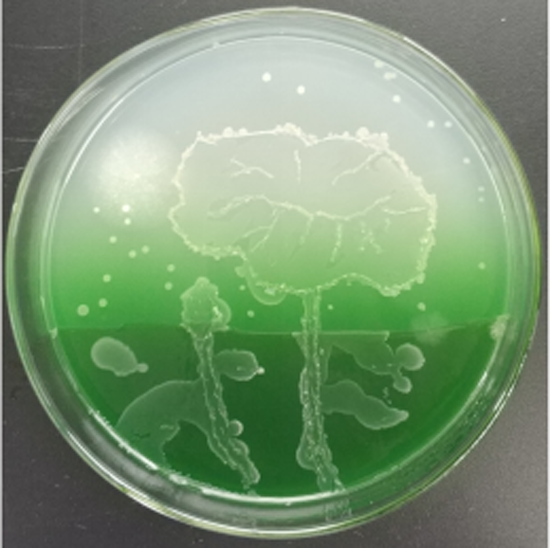

发布日期:2019-04-30 09:51 浏览量:
日前,由中国科技馆组织的”第六届全国青年科普创新实验暨作品大赛“拉开帷幕,食品检测系师生积极参与大学组“生物环境”命题组”细菌画“赛项,比赛要求以“初心”为主题,制作“细菌画”,即以培养基为画板,使在培养基上生长的、呈现不同颜色的微生物组成各种各样的图案,从而形成完整的画作,综合考察大学生微生物知识、动手实验能力、艺术设计能力和团队协作能力。当严谨的科学实验遇到浪漫的艺术创作,会碰撞出怎样的火花?
食品检测系师生30余人组成12支团队,微生物学任课教师与微生物学实验技术人员倾心指导。为了获得丰富色彩、展现创意,参赛师生废寝忘食,一起探讨创意方案,一起设计图画初稿,并尝试从各种环境中分离不同种类和颜色的菌种,力求图案创意独特、色彩丰富。






他们在实践中摸索,一次次失败,一次次重新来过。培养皿上逐渐呈现出一幅幅美丽的图案。最终成功的作品,既有纪念改革开放40周年的宏伟天安门,也有展现坚守初心、勇往直前精神的“行走”,更有用出淤泥而不染的莲花表现的“初心不染”……

食品营养与检测专业大一学生张苗苗说:“参与此次比赛,不仅巩固了专业知识,提升了实验操作技能,在审美能力、合作精神方面都有提升,感谢老师们坚守育人初心,指导和激励他们不断学习,以后会以更大的热情、更积极的心态投入到青春的学习和奋斗中!”